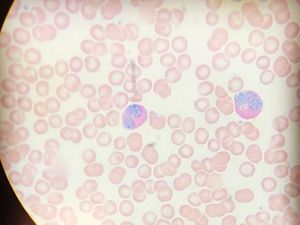
Foto: Ketika Sel Imun Tertangkap Lensa Mikroskop

detikEduSelasa, 07 Okt 2025 17:00 WIB
detikEduSelasa, 07 Okt 2025 17:00 WIB
Sosok 3 Ilmuwan Pemenang Nobel Fisiologi atau Kedokteran 2025, Ini Penemuannya
Inilah anugerah Nobel 2025 kategori fisiologi atau kedokteran. Siapa saja pemenangnya?
 detikEduSelasa, 07 Okt 2025 17:00 WIB
detikEduSelasa, 07 Okt 2025 17:00 WIB
Inilah anugerah Nobel 2025 kategori fisiologi atau kedokteran. Siapa saja pemenangnya?
 detikEduSenin, 13 Nov 2023 08:30 WIB
detikEduSenin, 13 Nov 2023 08:30 WIB
Para peneliti mencoba menghitung jumlah dan berat sel imun tubuh manusia. Hasilnya mengejutkan!
 detikHealthSelasa, 19 Jun 2018 13:03 WIB
detikHealthSelasa, 19 Jun 2018 13:03 WIB
Banyak tertawa tak hanya membuat pikiran lebih positif dan mood lebih baik. Studi mengungkap banyak tertawa juga bikin sel imun lebih kuat.
detikHealthSelasa, 05 Des 2017 09:05 WIB
detikHealthSelasa, 05 Des 2017 09:05 WIB
Sel imun berperan dalam memerangi segala virus dan bakteri jahat yang menyerang tubuh. Ini jadinya ketika sel tersebut diabadikan di bawah lensa mikroskop.